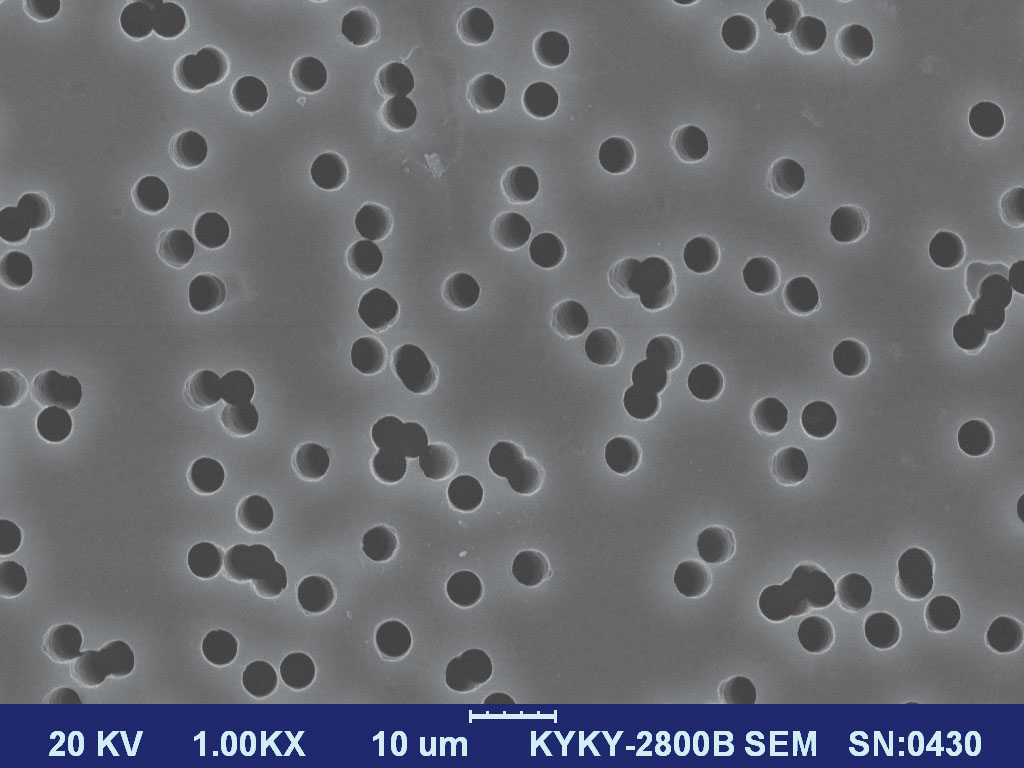

微孔濾膜
重離子微孔膜
也叫核孔膜,是一種新型的過濾膜。它的濾孔幾何形狀規則,孔徑均勻,基本是圓柱形的直通孔,過濾時大于孔徑的微粒被截留在濾膜表面,適宜橫向流過濾或反沖,以提高濾膜壽命。又由于濾膜本身是電介質薄膜,就不存在濾膜本身對濾液的污染,所以是精密過濾和篩分粒子的理想工具。
人 氣:1402
一、重離子膜特性
1.重離子微孔膜簡介
重離子微孔膜是一種新型的過濾膜。它的濾孔幾何形狀規則,孔徑均勻,基本是圓柱形的直通孔,過濾時大于孔徑的微粒被截留在濾膜表面,適宜橫向流過濾或反沖,以提高濾膜壽命。又由于濾膜本身是電介質薄膜,就不存在濾膜本身對濾液的污染,所以是精密過濾和篩分粒子的理想工具。
2.形成原理
重離子穿透塑料薄膜時,由于與受照物質原子的庫侖相互作用,在其沿途路徑上形成輻射損傷,損傷區直徑約為3~5納米。
化學蝕刻形成通孔,孔徑精確可控,孔徑范圍10納米~幾十微米。
微孔隨機分布,孔徑精確、均一,形狀規則,孔密度104~1011/cm2。
3.重離子微孔膜特性
★孔徑均一(孔徑精度±0.2μm);
★流量大(厚度相對較薄,流量>800ml/cm2*10min);
★無二次污染(無纖維脫落);
★化學穩定性好(耐酸、有機溶劑);
★熱穩定性好;
★生物學特性好;
★機械強度高、柔性好;
★自重輕、重量一致性好;吸水性低、灰分少(不易受潮變質)。



二、產品:
1.精密過濾輸液用膜。
常用過濾精度:5微米,3微米,2微米。其余孔徑可定制。
2.液基細胞學檢測用膜。
常用過濾精度:11微米,8微米,5微米。其余孔徑可定制。
3.實驗室篩分用膜。
4.藥業、釀造、食品行業用膜。
5. PM2.5可吸入顆粒物過濾用膜。
6.水處理用膜。
7.防偽用膜。
三、產品圖片:




上一條:沒有啦
下一條:沒有啦